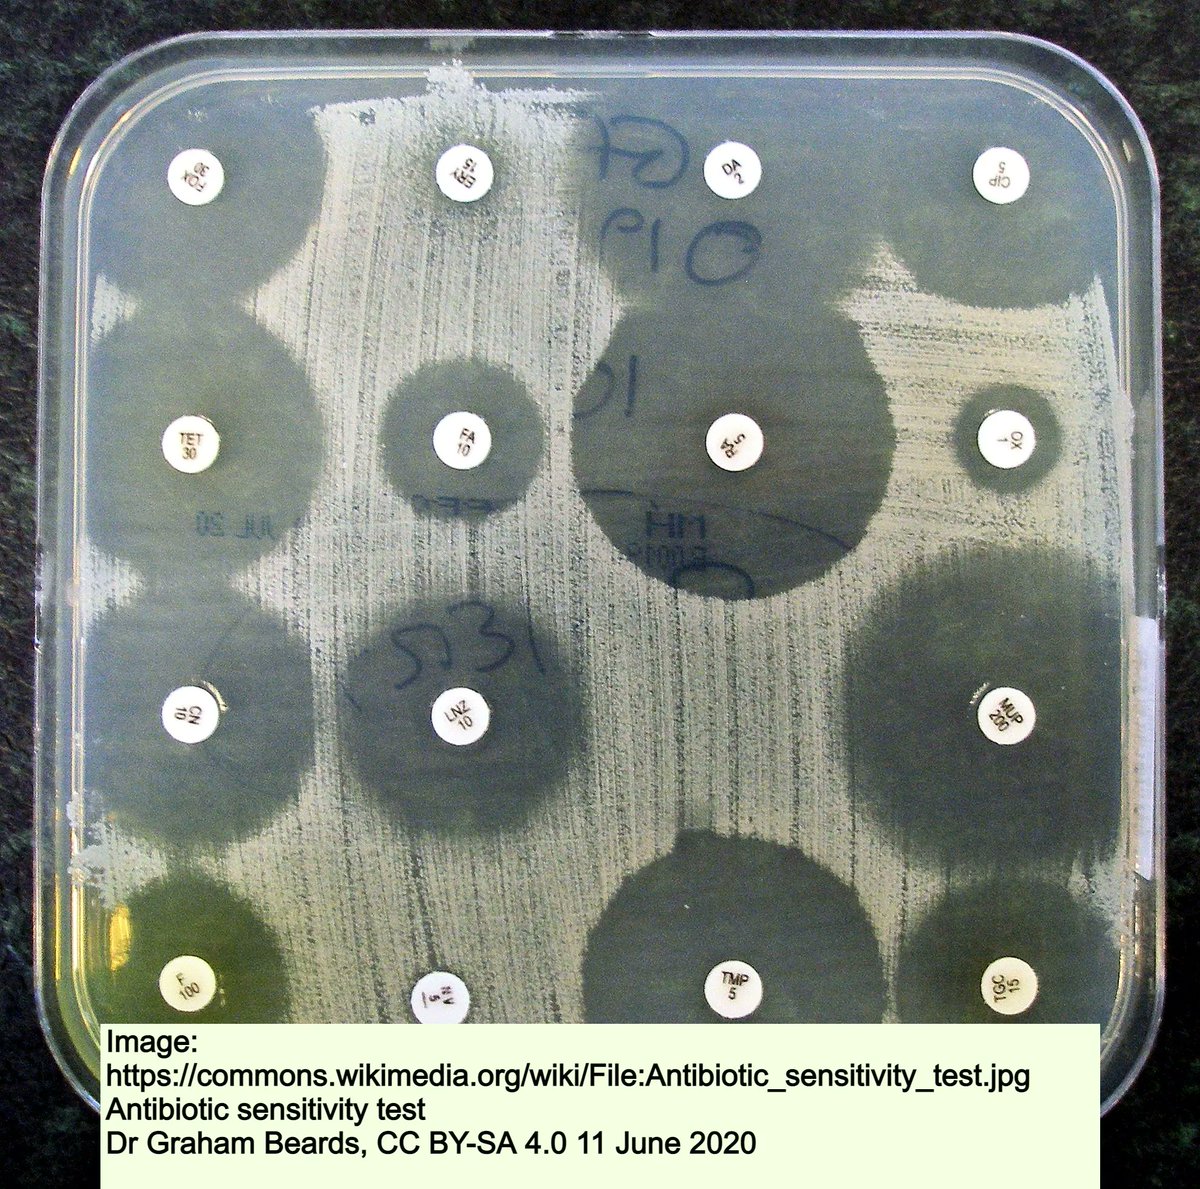
DocAliceWrites's tweet image. Resistance is futile! 
Drugs that once killed germs are losing potency. In 2019 #AntimicrobialResistance directly caused the deaths of 1.3m people worldwide–more than HIV/AIDS or malaria alone.
Fast facts here: buff.ly/3FTKwt2 

#WAAW2022 @CDCgov @NaturePortfolio @ACSQHC

Alice Lam
@DocAliceWrites
UK-trained GP and medical writer. Passionate about telehealth, accredited education for doctors, patient resources and web copy. Digital health enthusiast.
You might like
TW: Over 700,000 take their lives every year, and suicide is the third leading cause of death in people aged between 15 and 29. Please talk to someone if you are feeling depressed, anxious or suicidal. You are not alone. #worldsuicidepreventionday #WSPD2024

HealthCert Education is now a major CPD provider for the Royal Australian College of General Practitioners (RACGP). As a HealthCert GP educator, I'm excited to be part of this milestone event.

Totally agree. I'm just as passionate that patients have regular blood and urine checks - sadly not always being done in primary care. A campaign to increase awareness in general practice and patients could save lives and prevent serious complications.
Regional and remote areas are reporting nearly 4 times the rate of hospitalisations than people living in Northern Sydney. @DiabetesAus CEO Justine Cain says the findings point to an urgent need for a National #Diabetes #Kidney Disease Screening Program. diabetesaustralia.com.au/news/the-bush-…

Plus, so much more. What does healing look like for you? 💚

GPs specialise in mental health as undifferentiated, often complex presentations. Respect our work.
Quote “70% of GP consultations involve a mental health issue, and more people receive mental health treatment from their GP than from psychologists & psychiatrists combined. Mental health generalism is different to psychiatry, psychology or social work. insightplus.mja.com.au/2023/9/gps-rol…
If you have bipolar disorder, watch this @IntlBipolar webinar. @askvasavi shares her wisdom on living with BD - being in tune with energy and creativity, being mindful of self-talk, whilst keeping it real. buff.ly/3L5RVId #bipolarawareness #bipolarlife #bipolardisorder
Will you benefit from a COVID booster this year? What about the new subvariants and will any vaccine do the job? Check out my summary of ATAGI's recently released advice along with other COVID top facts at buff.ly/3xaO8kG @healthgovau

#HepatitisB is still infecting hundreds of thousands of babies every year. The hepatitis B birth dose vaccine is urgent.
An open letter to @gavi: hepatitis B birth dose vaccine can’t wait Signed by @CDAFound @GlobalHep @HepAus @EndHep2030 @HepBFoundation @MSF_access @PATHtweets #TREATAsia @amfAR @uicc @Hep_Alliance thelancet.com/journals/langa… #nohep #endhep #HBV @GaviSeth

The tragedy triggered New Zealand into announcing a permanent ban on the export of livestock by sea. ab.co/3VMsiyL
Around 38 million people live with #HIV worldwide, although more than 1:10 don't know they have it. Treatment can lead to viral suppression which means a long and healthy life. Untreated, #AIDS (late-stage HIV) can develop, with a 3-year survival rate. Test & treat early. @HIVGov

Q: Which cancer kills the most Australians in 2020? Lung cancer - with those affected having only a 1 in 5 chance of surviving another five years. Smoking is found in up to 9 out of 10 cases - so quit now. @CancerAustralia #LungCancerAwarenessMonth #StopSmoking

Resistance is futile! Drugs that once killed germs are losing potency. In 2019 #AntimicrobialResistance directly caused the deaths of 1.3m people worldwide–more than HIV/AIDS or malaria alone. Fast facts here: buff.ly/3FTKwt2 #WAAW2022 @CDCgov @NaturePortfolio @ACSQHC

We must not feed #antibiotic resistance. Where is the evidence this plan is more efficacious and safe than seeing a #GP?
Yet another reason why the NSW pharmacy prescribing plan should not do ahead. We should be fighting anti microbial resistance not enabling it by handing pharmacists the power to prescribe antibiotics behind the backs of GPs. Stop this madness, patient safety is at stake.
This Saturday is #WorldPneumoniaDay! #Pneumonia kills 2.5M people annually worldwide, those aged ≥70 being at highest risk. Social distancing, good hygiene, and #Influenza #Covid #Pneumonia #vaccinations protect your lungs. @CDCgov buff.ly/3eXUMW8

A whopping 1 in 10 adults worldwide lives with #diabetes. This figure is expected to increase by nearly 50% by 2045. Want to learn more? Check your national diabetes organisation’s resources. @DiabetesAus @CDCgov @US_FDA #WorldDiabetesDay #EducationToProtect #diabetesawareness
Today is the last day of #BreastCancerAwareness Month. But don’t forget, #BreastCancer is the most common cancer type globally, affecting 1 in 8 women. Check out these prevention tips. @NBCF @WisconsinCancer #BreastCancerAwarenessMonth Infographic: buff.ly/3CP0bXg

Guess what? Doctors are humans too. They need your support, especially in crisis.
My heart is absolutely breaking for the doctors of Lismore. All of those who lost their practices contacted me last week in despair about the anti-doctor media coverage and now they face floods again and still no support. #vastmajorityofdoctors
Thanks @AusMedWriters and @EnvisionPatient for this useful webinar. #PlainLanguageSummaries = information for all
There’s a #toolkit for development of PLS! Thank you @EnvisionPharma & @AusMedWriters such an excellent webinar!

#PlainLanguageSummaries are increasingly used in publishing to boost clinical management. linkedin.com/company/future… @futuresciencegp @fsgnmt #AlzheimersDisease #physician #practitioner
Two new #PlainLanguageSummaries have been published in @fsgnmt to help physicians and practitioners diagnosing and treating of #AlzheimersDisease learn about new ways to diagnose the condition. Read the summaries here: 📖 – bit.ly/3b4rKC7 📖 – bit.ly/3ovqyuF

Everyone experiences bone thinning after middle age. It can cause easy fractures and disability. See how to reduce your risk here: buff.ly/3esHy3f @iofbonehealth #worldosteoporosisday #NoMoreBrokenBones #StepUpForBonehealth #Osteoporosis


United States Trends
- 1. Happy New Year's Eve 17,4 B posts
- 2. Lakers 41,5 B posts
- 3. annabeth 12 B posts
- 4. percy 17,1 B posts
- 5. Lincoln Riley 3.594 posts
- 6. #MiraclesAblazeDay2 25,6 B posts
- 7. Pistons 9.706 posts
- 8. #LingOrmHNYatICONSIAM 2,36 Mn posts
- 9. #RIZIN 16,4 B posts
- 10. Happy NYE 4.395 posts
- 11. #TAXSTRIKE 4.005 posts
- 12. #AlamoBowl 1.008 posts
- 13. Whale - Buy 2.622 posts
- 14. grover 2.556 posts
- 15. The 4D 237 B posts
- 16. hyuna 5.792 posts
- 17. 5m TXs 1.064 posts
- 18. Bangkok 122 B posts
- 19. Ayton 3.231 posts
- 20. OutKast 1.197 posts
Something went wrong.
Something went wrong.












































































